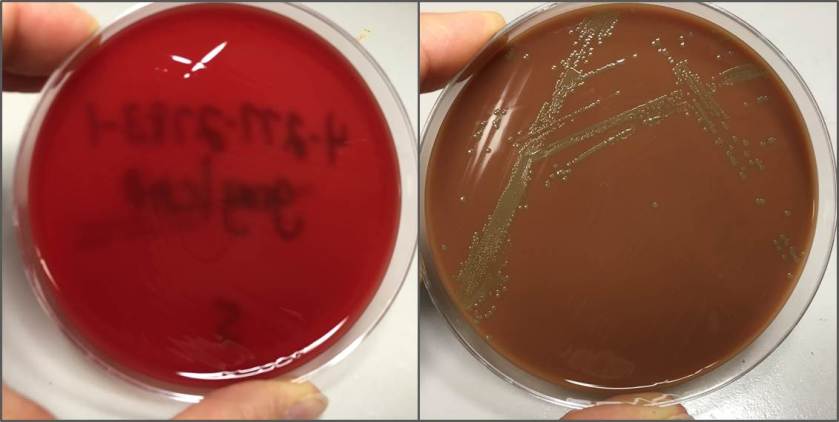
gran2

Case History
A 15-year-old male patient with acute myeloid leukemia (AML) had a central line placed for chemotherapy and subsequently developed symptoms of fever, abdominal pain, and diarrhea a few weeks later. He was treated with metronidazole for intra-abdominal infection and experienced improvement in diarrhea and abdominal pain, however his fever remained. Blood cultures were drawn from his central line and were positive.

Figure 1. Gram stain of the positive blood culture showing Gram-variable cocci in pairs and chains
Figure 2. Growth profile on organism on 5% sheep blood and chocolate agars

Figure 3. Colony Gram stain demonstrating pleomorphic, Gram-variable cocci in pairs and short chains
Laboratory diagnosis
Gram stain of the blood specimen revealed Gram-variable cocci in pairs and chains (Figure 1). The specimen was cultured on 5% sheep blood, chocolate blood, MacConkey, and Columbia colistin nalidix agar (CNA) agars. The next day, growth of small, round, grey colonies was seen only on the chocolate agar (Figure 2). Catalase test was negative. MALDI-TOF (Matrix Assisted Laser Desorption/Ionization, Time-of-Flight) identified Granulicatella adiacens with a 2.267 match score.
Discussion
The Granulicatella genus is a former member of the Abiotrophia genus, previously known as nutritionally variant or satelliting streptococci. The Granulicatella genera consists of G. adiacens and G. elegans (formerly A. adiacens and A. elegans respectively); of the Abiotrophia genus, only A. defectiva remains. These organisms are normal flora of the oral cavity, upper respiratory tract, gastrointestinal tract, and genitourinary tract. Granulicatella endocarditis is an uncommon, but well-documented phenomenon of both native and prosthetic valves and accounts for 5-6% of all streptococcal endocarditis. Other potential complications include ocular, central nervous system, musculoskeletal infections, bacteremia, pneumonia, scrotal abscess, septic arthritis, peritoneal dialysis-associated peritonitis, and breast-implant associated infections.
The Granulicatella spp. are catalase-negative, oxidase-negative, facultative anaerobic, gram-positive coccobacillus arranged in pairs and chains; although pleomorphism may occur (Figure 3, colony Gram stain). Notably, Granulicatella will grow on chocolate blood agar, but not 5% sheep blood agar or CNA agar because it requires Pyridoxine or vitamin B6 for growth. In addition to chocolate agar, Granulicatella can grow on Brucella agar with 5% horse blood and in thioglyconate broth. Granulicatella and other nutritionally variant streptococci exhibit satelliting behavior. Satellite testing is performed on a media that supports no or little growth of Granulicatella (e.g. sheep blood agar). A single streak of Staphyloccous aureus across an area of the media inoculated with Granulicatella is incubated at 35°C in a high CO2 atmosphere. Granulicatella will grow only in the vicinity of S. aureus growth. An alternate test for satelliting involves supplementation of media with pyridoxine hydrochloride, to allow growth of Granulicatella.
Biochemical reactions include: pyrrolidonyl arylamidase production (PYR) positive, leucine aminopeptidase production (LAP) positive, 6.5% NaCl negative, and bile esculin negative. Species identification is accomplished by arginine hydrolysis (ARG) and beta-glucuronidase (BGUR) activity testing. G. elegans is ARG-positive, while G. adiacens and Abitrophia are both negative. G. adiacens is further identified by a positive BGUR analysis, and Abiotrophia is again negative.
Abiotrophia and Granulicatella have shown variable susceptibility to both penicillin and aminoglycoside antibiotics. There is documented resistance to clindamycin, tetracycline, erythromycin, and ciprofloxacin, but not to rifampin or vancomycin. Current recommendations are to treat similarly as for enterococcal endocarditis using a combination therapy of a beta-lactam antibiotic with an aminoglycoside antibiotic, such as penicillin plus gentamycin. Unfortunately, relapse rates appear high despite appropriate treatment.
The likely source of this patient’s Granulicatella bacteremia is bacterial translocation from the gut in the setting of an immunocompromised state. The work up for a central line source of the bacteremia is still currently in progress, and echocardiogram was negative for vegetation. He is currently being treated with vancomycin for bacteremia, and cefepime and metronidazole for intra-abdominal infection.
References
- Ruoff, K. Aerococcus, Abiotrophia, and other aerobic catalase-negative, gram-positive cocci. Manual of Clinical Microbiology, 10th Edition(pp. 365–376). American Society of Microbiology.
- Procop, G. W., Church, D. L., Hall, G. S., Janda, W. M., Koneman, E. W., Schreckenberger, P. C., & Woods, G. L. (2016). Koneman’s Color Atlas and Textbook of Diagnostic Microbiology(7th ed.). Philadelphia: Wolters Kluwer.
- Cargill, J., Scott, K., Gascoyne-Binzi, D., Sandoe, J. “Granulicatella infections: diagnosis and management.” Journal of Medical Microbiology 16 (2012): 755-761.
-Melinda Flores, MD, is a 1st year clinical and anatomic pathology resident at the University of Texas Southwestern Medical Center, Dallas, Texas.

-Erin McElvania TeKippe, PhD, D(ABMM), is the Director of Clinical Microbiology at Children’s Medical Center in Dallas Texas and an Assistant Professor of Pathology and Pediatrics at University of Texas Southwestern Medical Center.
thanks melinda, good luck
Thanks